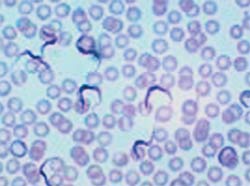
http://www.nkj.ru/upload/iblock/f71/f7118df185bc67a425d3462478921742.jpg

Пять тайн Луны
Единственное из небесных тел Вселенной, на котором побывал человек, - это Луна, спутник нашей планеты. Селена, как называли Луну древние, находится под пристальным вниманием телескопов, ее изучают с Земли и из космоса, ко, по оценке самих же ученых, наши знания о Луне за последние четыре десятилетия возросли не намного, а количество загадок, окружающих эту планету, не уменьшилось, а, наоборот, возросло.
После того, как американцы свернули долгосрочную программу "Аполлон", понемногу о Луне начали забывать - астронавтика устремилась в другие области. Однако Луна не давала забыть о себе совсем, все чаще и чаще подбрасывая ученым неразрешимые загадки. Наибольшее замешательство вызвал случай с запущенным несколько лет назад автоматическим зондом "Клементина-II", уникальным детищем НАСА. Целью путешествия зонда являлось испытание передовых технологических разработок, в частности новейших суперчувствительных измерительных приборов. "Клементина" сфотографировала Луну с высоты 400 километров, а затем двинулась в направлении астроида 1620 Geographos.
Присланные же зондом на Землю снимки вызвали бурю удивления среди мужей науки: на дне нескольких кратеров, расположенных в южном полушарии Луны, вероятно, находится... замерзшая вода! Это была сенсация тех недалеких от нас лет - ведь Луна традиционно считалась мертвым телом. Условия Луны, казалось, полностью исключают саму возможность образования льда. Интересуетесь, почему?
Дело в том, что лунные сутки в 28 раз длиннее земных. За этот период вся поверхность нашего спутника во время лунного дня бывает освещена Солнцем, причем атмосферы на Луне нет, и температура поверхности может достигать плюс 122 градуса Цельсия! Как же здесь образоваться льду?! Однако сделанные зондом снимки указывали на то, что лед мог сохраняться в тех местах, которых не достигают солнечные лучи, например, не дне глубоких кратеров. В южном полушарии Луны находится гигантский кратер диаметром 2500 км и глубиной 12 км, причем дно этого огромного бассейна усеяно углублениями поменьше. Вот в этих углублениях и был обнаружен лед, и именно лед, убеждены ученые. Но опять-таки откуда вода на Луне?! Высказывается мнение, что она могла попасть туда вместе с метеоритами, на протяжении миллиардов лет бомбардирующих поверхность Селены. Часть льда давным-давно испарилась, а другая могла законсервироваться на дне кратеров. Но гипотетическая вода на Луне - это только одна из загадок этой планеты.
Специалисты НАСА сформулировали пять главных тайн Луны, над разгадкой которых в ближайшие годы будет работать наука - как Луна стала спутником Земли? Какова история Луны? Когда и как на Луне появились кратеры такой невероятной глубины? Какие загадки Солнечной системы связаны с Луной? Как можно видеть, эти тайны в основном связаны с прошлым Луны. А что говорят ученые о будущем этого земного сателлита?
...Люди, дома, деревья, целые скалы, как будто сорванные со своего места небывало сильным ураганом, падали, рушились, разлетались в прах, все сметая на своем пути. И хотя сама планета уцелела, в несколько мгновений на ней не осталось ни единого живого существа, которых миллионы лет до того заботливо пестовала природа... Перед этим глобальным катаклизмом никто не сможет устоять, невзирая на то, какие бы технические средства защиты он не использовал. Перед лицом этой катастрофы меркнут ужасы, описанные в Апокалипсисе, и каждый день приближает к ней землян. И исходит эта угроза от... Луны, спутницы нашей планеты.
Влияние Луны на жизнь человеческую изучали и изучают традиционные и нетрадиционные науки. Луну мы привыкли считать естественным спутником Земли, в сущности не имеющего отношения к нашим судьбам. Эта маленькая, пустынная планетка (в 4 раза меньше Земли), чья поверхность изборождена кратерами и которая пассивно кружится вокруг Земли, повинуясь закону притяжения. Чем она может нам угрожать?!
Луна удалена от Земли на расстояние в 384 тысячи километров и имеет диаметр в 3476 километров, что вчетверо меньше диаметра Земли. Но не только Земля притягивает Луну, но и Луна, в соответствии со всеми законами физики, притягивает Землю. Получается так, что Луна кружит вокруг нас, а мы - вокруг нее, и связаны обе планеты неразрывно. И хотя присутствие Луны является необходимым условием для удержания Земли в Солнечной системе, цена за эту "услугу" - неизбежное убийство всего живого на Земле, которое эта планета-карлик когда-нибудь совершит. А орудием убийства явится ничтожная сила притяжения Луны. Когда таинственная Селена проплывает в ночном небе над нашими головами, она притягивает к себе все, что попадает в ее гравитационное поле. Самым ярким проявлением того служат приливы и отливы океана. Луна притягивает к себе огромные массы воды, и тогда наступает отлив. А когда она, кружась по орбите, отдаляется от Земли, "выпуская" Мировой океан из своего гравитационного поля, наступает прилив. Но то, что кажется нам естественным движением воды, в сущности является движением Земли. Ведь получается как: когда Луна держит в своем поле вздыбившийся океан, Земля продолжает вращаться вокруг своей оси, поэтому не вода движется к материкам, а, наоборот, материки к воде. И с каждым разом, когда Луна тянет к себе наши океаны, Земля, вращаясь, вынуждена преодолевать силу трения "стоящих дыбом" на ее поверхности водяных гор. И с каждым таким усилием Земля теряет скорость оборотов вокруг своей оси, и уже никогда не обретет прежней скорости...
Замедление вращения Земли в этой связи составляет 0,0016 секунды ежедневно, и это торможение длится уже несколько миллиардов лет! Представляя все большую и большую угрозу для нашей планеты. Увы, сегодня с каждым днем приближается тот роковой день, когда Селена окончательно "нажмет на тормоз". Чтобы понять, как это будет выглядеть, припомните свои ощущения, когда водитель несущегося на полной скорости переполненного автобуса вдруг тормозит, и все валятся в кучу. Разве кто-нибудь или что-нибудь сумеет устоять тогда под натиском сорванных внезапным торможением с места гор и океанов...
По представлению большинства эзотерических учений, Луна станет следующей планетой, на которой разовьется жизнь, однако не в физической, а в духовной (ментальной) форме. Она пока только готовится к этой роли, накопляя в себе как можно больше энергии. Одним из главных источников этой энергии является Земля и происходящие на ней процессы жизни и смерти. Ведущие эзотерики учат, что при жизни человека Луна контролирует его поступки и действия; инспирации Луны во многом являются мотивацией событий на Земле. Даже в обычных ситуациях мы не всегда способны освободиться от ее влияния
Добро пожаловать!!!